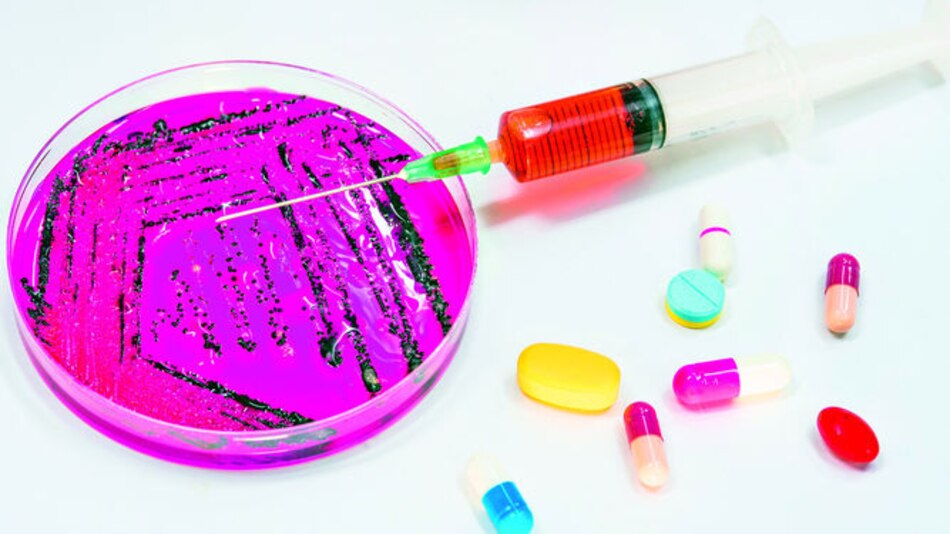
Líquenes de la Antártida contra superbacterias

Expuestos a bajísimas temperaturas y a condiciones climáticas extremas, los líquenes que crecen en la Antártida pueden convertirse en la esperanza para combatir las “superbacterias”, resistentes a los antibióticos y que se están convirtiendo en una nueva amenaza para la salud humana.
Dominantes en la flora terrestre antártica, los líquenes -surgidos de la simbiosis entre un alga y un hongo- producen gran cantidad de compuestos, conocidos como “metabolitos secundarios” para sobrevivir en hábitats inhóspitos. Sus propiedades resultan útiles en ambientes polares y de alta montaña, entre las que se encuentran la protección contra radiación ultravioleta, actividad antioxidante, antimicrobiana o anticancerígena.
Los científicos chilenos Angélica Casanova-Katny, Xabier Villanueva y Gerardo González-Rocha estudian estas propiedades para crear un antídoto para las bacterias multirresistentes, que según la Organización Mundial de la Salud pueden matar a 10 millones de personas para 2050.
Pero no todos los líquenes que crecen en las rocas, los musgos o la tierra del continente blanco tienen las mismas propiedades, dice la ecofisióloga Casanova-Katny. Entre los líquenes procedentes de la península Fildes, en la isla Rey Jorge, uno de los más efectivos ha resultado ser el H. lugubris, que se ha probado contra dos cepas bacterianas resistentes a los antibióticos (Kocuria rizophila ATCC 9341 y A. baumannii ATCC 19606).